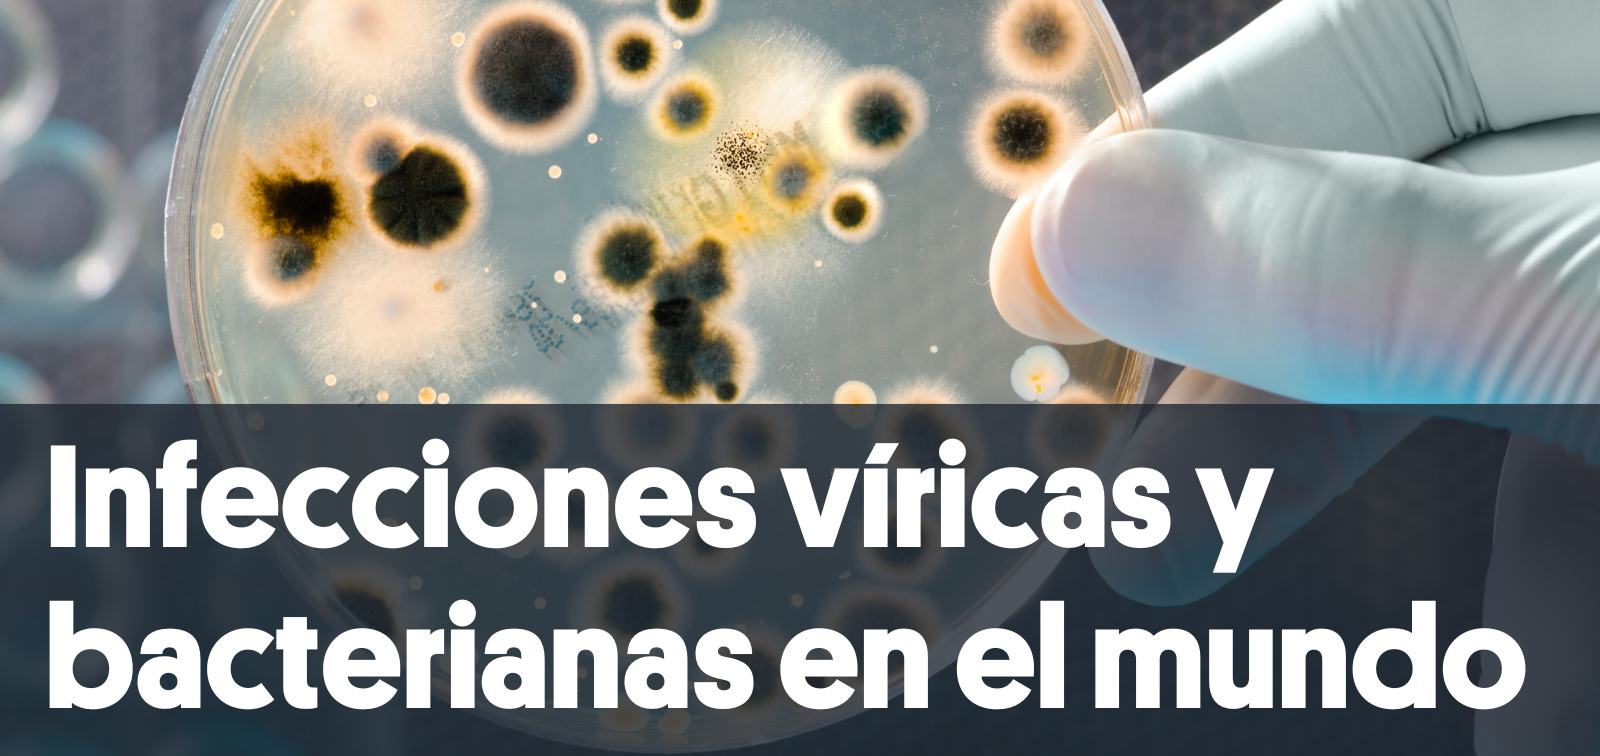
Imagen web de los programas de investigación de ISGlobal

Las enfermedades infecciosas están causadas por microorganismos patógenos, como bacterias, virus, parásitos u hongos, y pueden transmitirse directa o indirectamente de una persona a otra. A pesar de los avances médicos, las enfermedades infecciosas víricas y bacterianas siguen siendo una de las principales causas de muerte en todo el mundo.
El programa de Infecciones Virales y Bacterianas de ISGlobal consta de 15 grupos de investigación que trabajan en una amplia gama de patógenos virales y bacterianos, y comprende una amplia cartera de investigación multidisciplinar y traslacional que va desde la ciencia básica a la investigación clínica, epidemiológica y orientada a la salud pública. Nuestro principal objetivo es reducir la carga de las principales enfermedades víricas y bacterianas proporcionando a la sociedad nuevas herramientas de prevención, diagnóstico y tratamiento.
Objetivos específicos
- Mejorar el conocimiento de la fisiopatología y la biología molecular de los patógenos.
- Diseñar y desarrollar nuevas herramientas para la prevención, el diagnóstico y el tratamiento de las principales infecciones víricas y bacterianas.
- Comprender la respuesta inmunitaria y el papel de la microbiota frente a estas infecciones.
- Mediante la ciencia de la implementación, desarrollar y evaluar estrategias para la realización de intervenciones de eficacia probada.
El programa, a través de sus grupos de investigación, tiene una notable presencia internacional al pertenecer a importantes redes como B2B2B AMRx, al organizar y participar en seminarios, conferencias y talleres internacionales, y al coordinar y/o participar como socios en proyectos clave financiados por agencias internacionales como Horizon Europe (por ejemplo, EChiLiBRiST), NIH, EDCTP (por ejemplo, EXULTANT, Stool4TB), Bill and Belinda Gates (ICARIA), proyectos ANTICOV.
Además, la mayoría de los Investigadores Principales del programa colaboran con otros programas de ISGlobal para desarrollar proyectos e ideas, incluyendo aquellos que no tienen una segunda afiliación.
Principales líneas de investigación
El programa abarca una serie de disciplinas que resultan cruciales para avanzar en nuestra comprensión y respuesta a las enfermedades infecciosas virales y bacterianas. En biología molecular y fisiopatología, estudiamos las intrincadas formas en que diferentes microorganismos patógenos infectan nuestro cuerpo, causando enfermedades, y buscamos posibles dianas para desarrollar nuevos fármacos. Además, nuestro trabajo en inmunología e investigación del microbioma está desentrañando las interacciones entre la respuesta inmunitaria y la microbiota intestinal, arrojando luz sobre cómo influyen en la patogénesis y la virulencia de virus y bacterias. Este conocimiento es fundamental para comprender la protección natural frente a infecciones y enfermedades, o la susceptibilidad a ellas.
En cuanto al descubrimiento de fármacos, nuestra actividad incluye la exploración de moléculas de origen natural y sintético, incluidas pequeñas moléculas y péptidos, al tiempo que se identifican posibles dianas para nuevos candidatos a fármacos. Mediante estudios de epidemiología molecular y clínica, investigamos patrones de enfermedad, sus causas y su impacto en las poblaciones, así como la asociación entre exposiciones o tratamientos y resultados en salud. Este conocimiento es la base de las estrategias para reducir la carga de infección en poblaciones vulnerables y desarrollar guías de práctica clínica.
Nuestra experiencia se extiende al diseño, desarrollo y validación de herramientas de diagnóstico y cribado. Nuestro personal participa en diferentes etapas de la cadena de valor, desde el descubrimiento de biomarcadores hasta la validación de campo y la evaluación del impacto. El programa también desempeña un papel clave en el desarrollo de herramientas de tratamiento y prevención. Participamos activamente en ensayos clínicos de vacunas y fármacos en Europa, África y América Latina, según la epidemiología del patógeno y las necesidades de la población.
Por último, el interés del programa por el seguimiento y evaluación, la ciencia de la implementación y la salud pública nos permite desarrollar y evaluar estrategias eficaces para llevar a cabo intervenciones de eficacia probada.
Grupos de investigación
- Evaluación del imacto económico y en la salud (Davide Rasella y Elisa Sicuri)
- Infecciones bacterianas (Jordi Vila, Sara M. Soto y Quique Bassat)
- Infecciones maternas e infantiles (Clara Menéndez y Azucena Bardají)
- Infecciones virales (Mike Martínez y M. Angeles Marcos)
- Inmunología de la malaria (Carlota Dobaño y Gemma Moncunill)
- Micobacterias (Julià González y Griselda Tudó - Grupo Clínic Barcelona)
- Resistencia antimicrobiana (Jordi Vila, Sara M. Soto y Ignasi Roca)
- Salud del Migrante (Ana Requena)
- Salud y diagnóstico emergentes y digitales (Jose Muñoz, Claudio Parolo, Daniel Camprubí Ferrer, Pedro Fleitas)
- Grupo de salud pública y enfermedades hepáticas (Jeffrey Lazarus)
- Tuberculosis (Alberto García-Basteiro)
- VIH (Denise Naniche)
Traslación e impacto
Las actividades de traslación fueron lideradas por la Iniciativa de Resistencias Antimicrobianas hasta enero de 2026, cuando se integraron en el programa de Infecciones víricas y bacterianas en el mundo, reforzando aún más el compromiso de ISGlobal con un enfoque integral orientado a los resultados.
Historias de impacto relacionadas
Nuestro equipo
Dirección
-
Sara Soto González Associate Research Professor y directora del Programa de Infecciones Víricas y Bacterianas
Investigadores/as principales del programa
-
Miriam José Álvarez Associated Researcher
-
Azucena Bardají Associate Research Professor -
Quique Bassat Orellana Director general y científico -
Climent Casals-Pascual Associate Research Professor -
Silvia de Sanjosé Investigadora asociada -
Elizabeth Diago Navarro Investigadora Asociada -
Carlota Dobaño Research Professor -
Alberto García-Basteiro Research Professor -
Raquel González Associated Researcher -
Julià González Martín Associated Researcher
-
Jeffrey Lazarus Head of the Public Health Liver Group -
-
Elisa López Varela Associated Researcher -
Inácio Mandomando Investigador asociado
-
Mª Ángeles Marcos Associated Researcher -
ANGELA LUCIA MARTINEZ PEREZ
-
Miguel Martínez Medical Research Fellow -
CLARA MENENDEZ SANTOS
-
Gemma Moncunill Associate Research Professor -
Jose Muñoz Associate Research Professor -
Denise Naniche Research Professor -
Claudio Parolo Associated Researcher -
Otavio Ranzani Assistant Research Professor -
Davide Rasella ICREA Research Professor and Head of the Global Health Impact Assessment and Evaluation Group (IMPACThealth) -
Ana Requena Méndez Associate Research Professor -
Ignasi Roca Associated Researcher -
Elisa Sicuri Associate Research Professor -
Griselda Tudó Vilanova Associated Researcher
-
Jordi Vila Estapé Research Professor y director de la Iniciativa de Resistencias Antimicrobianas -
Anna Vilella Morato Associated Researcher
-
Anna Roca ICREA Research Professor